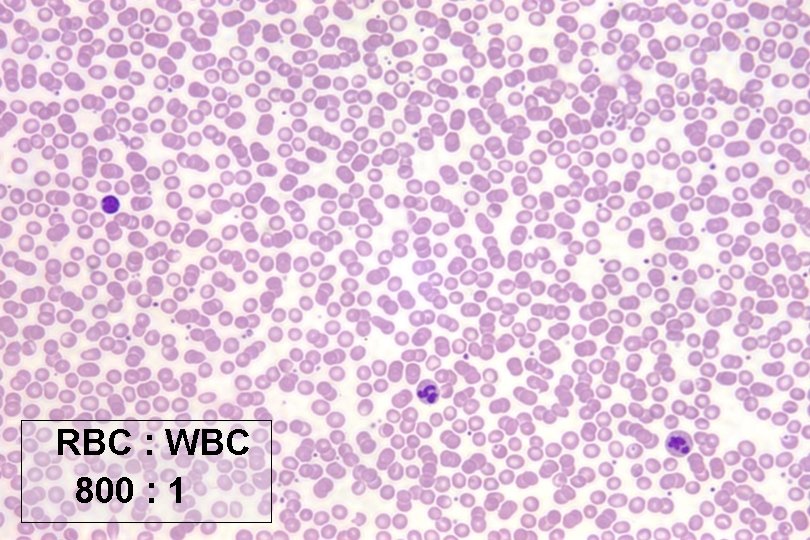
RBC : WBC 800 : 1 RBC : WBC 800 : 1
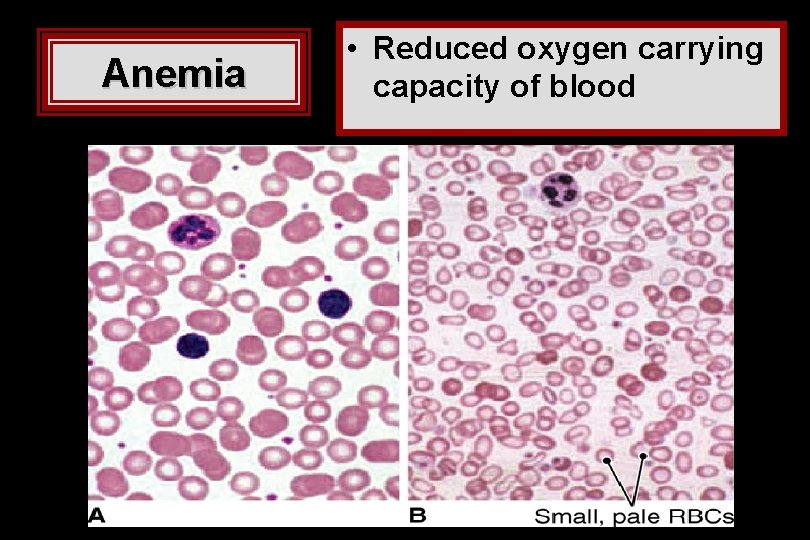
Anemia • Reduced oxygen carrying capacity of blood Anemia • Reduced oxygen carrying capacity of blood
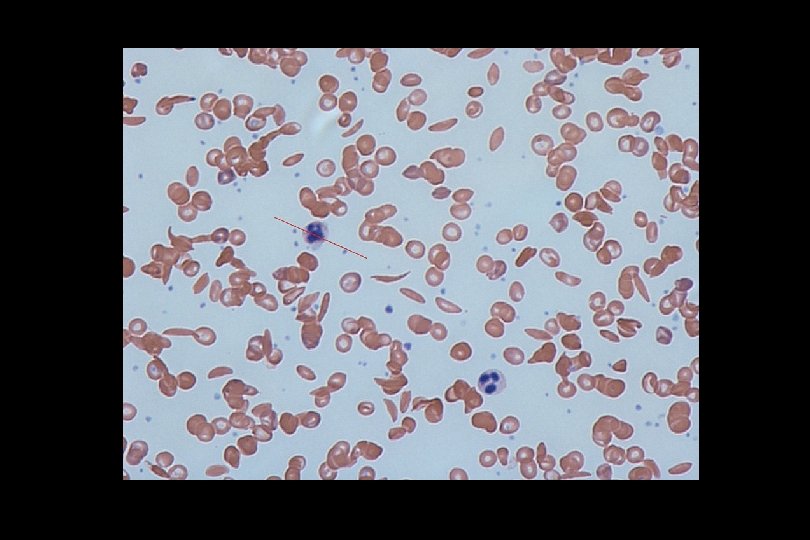
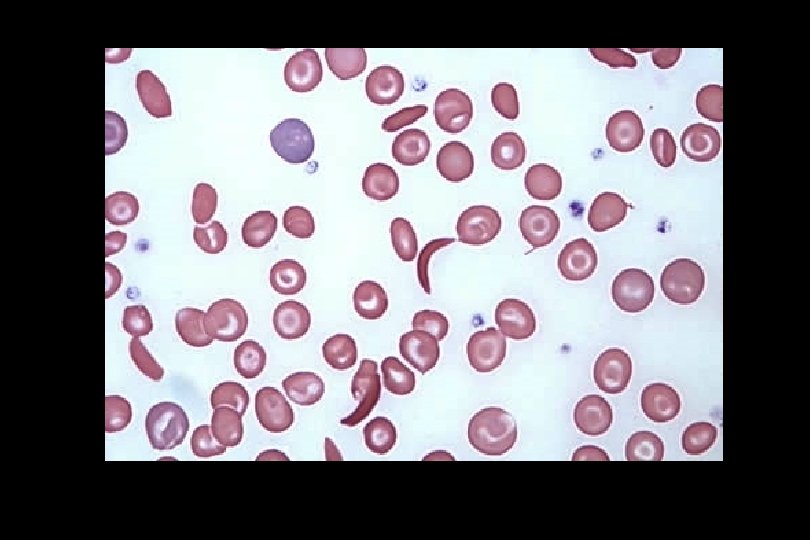

Blood Composition and Functions Composition of Blood 55

Blood Composition and Functions

Composition of Blood • 55% plasma nonliving fluid matrix • 45% erythrocytes RBC = red blood cell • Remainder 1% leukocytes WBC = white blood cell platelets cell fragments function in blood clotting

Blood is sticky, opaque, and salty. • bright to dark red • 5 x more viscous than water • p. H 7. 35 to 7. 45 slightly alkaline • 8% of body weight males 5 -6 L and females 4 -5 L • connective tissue because of its substance distribution functions

Functions of Blood

Distribution Functions 1. Transports O 2 from lungs to all body cells 2. Transports nutrients 3. Transport metabolic wastes from cells to kidneys or lungs 4. Transport hormones 5. Maintains body temperature - absorb and distribute heat

Protective Functions 1. maintain normal p. H 2. maintain adequate fluid volume 3. prevent blood loss 4. prevent infection

Hematopoiesis


Blood Formation • called hematopoiesis • occurs mainly in red bone marrow • flat and lg. long bones • cell numbers increase in response to need • all derive from stem cells called hemocytoblasts • maturation differs according to cell type • note degeneration of nuclei in RBC • After degeneration, nucleus is ejected and space where it was collapses to form concave region.

Erythrocytes Red Blood Cells

• O 2 transportation due to hemoglobin


• mature cells lack a nucleus • shape is biconcave which allows greatest surface area to volume • flexible so can fit through smallest capillaries
RBC : WBC 800 : 1

RBC formation triggered by: 1. hemorrhage which decreases the number of RBC 2. decreased availability of O 2 ex. high altitudes or pneumonia 3. increased tissue demand for O 2 ex. aerobic exercise


• iron and B vitamins are needed for hemoglobin synthesis

• RBC life span 100 - 120 days • broken down by phagocytes in spleen § hemoglobin is broken down to bilirubin § iron is saved, rest secreted in bile

Anemia • Reduced oxygen carrying capacity of blood


Symptoms: • • • Fatigue • Pale • Shortness of breath • Chills Weakness Shortness of breath Dizziness Fast or irregular heartbeat Pounding or "whooshing" in your ears • • Know these Headache Cold hands or feet Pale or yellow skin Chest pain

Common causes: § not enough RBC’s due to: § Hemorrhage § damage due to parasites § Infections § decrease hemoglobin due to lack of iron in diet § abnormal hemoglobin formation § sickle cell etc. . .

Anemia: Abnormal Hemoglobin

Genetics of Sickle Cell Anemia

- Slides: 27